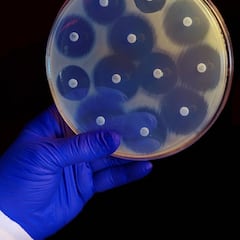
El aviso de la OMS sobre la ‘pandemia silenciosa’: así afecta el uso excesivo de antibióticos

Rusia ofrece un acuerdo “sin precedentes” a Irán y Corea del Norte
Desde EE.UU y Reino Unido ya han advertido de las “terribles consecuencias” que podría suponer la entrada de Irán y Corea en el conflicto.

Nuevas sospechas se ciernen sobre las relaciones entre Moscú, Teherán y Pyongyang. Tanto Estados Unidos como Reino Unido han informado de una más que posible colaboración entre los tres países con fines militares que buscarían desarrollar acuerdos para el intercambio y producción de armamento y aviones no tripulados de forma conjunta.
Según ha explicado John Kirby, portavoz del Consejo de Seguridad Nacional de Estados Unidos, Moscú estaría interesado en suministrar “equipos sofisticados” a Irán como helicópteros, sistemas de defensa antiaérea y aviones de combate a cambio del apoyo iraní en la producción conjunta de aviones en Rusia. Desde Washington aseguran que Irán estaría de acuerdo en vender “cientos de misiles balísticos” a Rusia en su invasión en Ucrania.
Drones iraníes
No es la primera vez que estas teorías se vierten por parte de organismos e inteligencias occidentales y es que, desde Reino Unido han asegurado que la intención de Rusia es conseguir más armamento por parte de Irán, algo que iría contra las sanciones de Naciones Unidas contra Teherán.
Russia’s growing military relationship with Iran has escalated aggression against Ukraine. Today, we designated Russian entities connected to the transfer of UAVs. We are using every tool at our disposal to disrupt this activity and impose costs on actors engaged in it.
— Secretary Antony Blinken (@SecBlinken) December 9, 2022
Desde el pasado mes de agosto, Barbara Woodward, embajadora británica en la ONU, afirmó que Rusia está recibiendo drones por parte de Irán con el fin de “matar a civiles y atacar infraestructuras civiles”, motivo por el que millones de ucranianos están sufriendo cortes de electricidad, que ahora se encuentran entre los problemas prioritarios para la población por los intensos fríos que asolan el país en esta época del año. Por su parte, desde Moscú y Teherán niegan estas acusaciones, aunque desde el país iraní reconocieron haber vendido drones a Rusia pero antes del inicio de la invasión.
Según el Ministerio de Defensa británico, Rusia habría recibido reabastecimiento de drones iraníes Shahed-131 y 136, de acuerdo con las informaciones recopiladas en las últimas tres semanas, donde se realizaron gran cantidad de ataques con este tipo de dispositivos.
Propuesta rusa
A cambio de este apoyo militar que sería de enorme ayuda para los tropas rusas, el gobierno del Kremlin estaría ofreciendo, tanto a Irán como a Corea del Norte, según las informaciones de Reino Unido, un apoyo técnico y militar “sin precedentes”. Para Woodward esto supone un gran problema: “Nos preocupa que Rusia tenga intención de dar a Irán componentes militares más avanzados, lo que permitiría a Irán reforzar su capacidad armamentística”, concluyó.
Noticias relacionadas
Esta alianza, ha sido catalogada por Estados Unidos como una situación “perjudicial” para el pueblo ucraniano, para el propio régimen iraní y, en definitiva, para el resto del mundo. Por otro lado, ayer se informó desde Washington del envío de otros 231 millones de libras para ayudar a las defensas aéreas ucranianas contra los drones, en lo que, desde la Casa Blanca, consideran como una alianza peligrosa y “que intentarán romper” de todas las maneras.
Desde la secretaría general de la OTAN, Jens Stoltenberg advirtió de que el conflicto podría tomar una deriva tremendamente peligrosa e incluso llegar a un punto de ‘no retorno’ en el caso de que se convierta en una guerra entre Rusia y la alianza occidental: “Si las cosas salen mal, pueden salir terriblemente mal por lo que estamos trabajando diariamente para evitar este escenario”, apuntó el mandatario de la ONU.